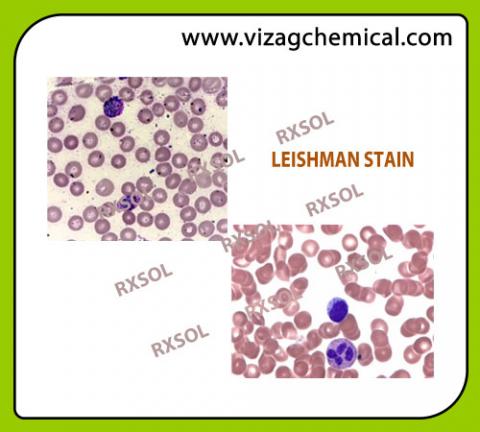

Primary tabs

LEISHMAN STAIN
Product Qty Per Unit:
25.00
Product usage unit:
Kg.PWD
Product Delivery Locations:
Visakhapatnam, Vijayawada, Kakinada, Gangavaram, Krishnapatnam, Rawa, Nellore, Rajahmundry
SKU:
RXSOL-69-1262-753 LEISHMAN STAIN
Product Description:
Leishman Stain excellent quality manufacturer, exporter and supplier. Leishman Stain is used in microscopy for staining blood smears. It provides excellent stain quality. It is generally used to differentiate and identify leucocytes, malaria parasites, and trypanosomas. It is based on a methanolic mixture of "polychromed" methylene blue. (i.e. demethylated into various azures) and eosin.The methanolic stock solution is stable and also serves the purpose of directly fixing the smear eliminating a prefixing step.
Leishman Stain excellent quality manufacturer, exporter and supplier. Leishman Stain is used in microscopy for staining blood smears. It provides excellent stain quality. It is generally used to differentiate and identify leucocytes, malaria parasites, and trypanosomas. It is based on a methanolic mixture of "polychromed" methylene blue. (i.e. demethylated into various azures) and eosin.The methanolic stock solution is stable and also serves the purpose of directly fixing the smear eliminating a prefixing step.
Product Application:
APPLICATION :
MICROSCOPICAL STAINING
Product Procedure:
Product Note:
Product pack size:
Product Technical Specification:
| C.A.S. No. | 12627-53-1 |
Specifications:
|
Product alias:
<p>
LEISHMAN STAIN</p>
Title:
LEISHMAN STAIN Remarks: